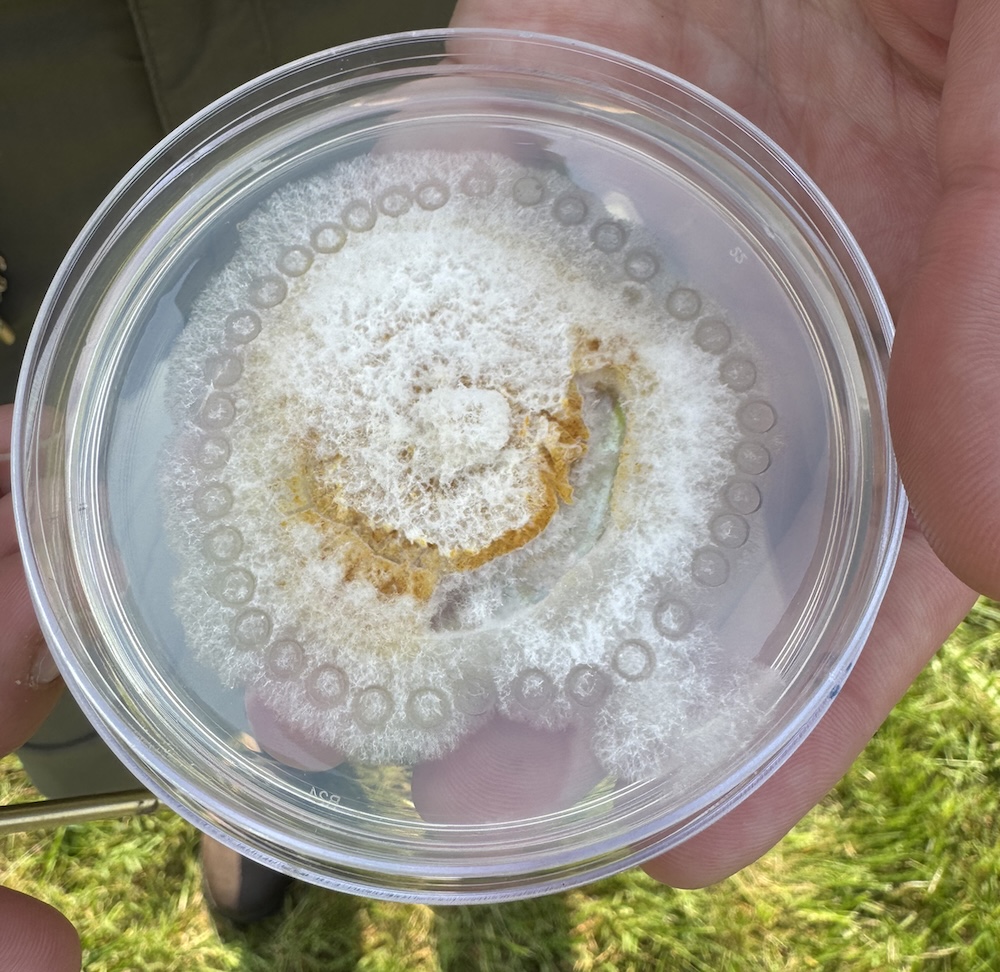
a petri dish with a white fungus inside

Virginia Master Naturalist Volunteers Lead Treemendous Forest Stewardship

Relevance
Forests are one of Virginia’s most important natural resources. More than 16 million acres of forestland cover over 62% of the state. In addition to commercial timber resources and economic benefits, Virginia’s forests provide critical ecosystem services, including water quality protection, carbon storage, wildlife habitat, and improved air quality. These benefits are increasingly threatened by loss of forestland, invasive species, poor management, and climate change. Education, science, and stewardship to address these threats are priorities for the Virginia Department of Forestry. Virginia Cooperative Extension’s Virginia Master Naturalist (VMN) program is well positioned to expand the agency’s capacity through volunteer service.
Response
The Virginia Master Naturalist (VMN) program is a statewide natural resource volunteer training and service program sponsored by Virginia Cooperative Extension, the Virginia Department of Forestry, and five other state agencies. More than 3,500 VMN volunteers across Virginia engage in environmental education, on-the-ground stewardship, and citizen science in their communities.
In 2025, the VMN program celebrated its 20th anniversary with a year‑long service focus on trees and forests. We chose this theme both to address threats to Virginia’s forests and to honor the 100th anniversary of forestry education, research, and outreach at Virginia Tech. As part of the “#Treemendous20th” theme, we promoted forest-focused service activities across the state, including educational events, citizen science projects, and stewardship opportunities such as tree plantings and invasive species management.
Results
VMN volunteers embraced the #Treemendous20th theme and delivered forest-related service across the Commonwealth. Their efforts resulted in thousands of trees planted or rescued, dozens of educational events that raised public awareness of the importance of trees, and contributions to six different forest-focused scientific studies.
Approximately 90 volunteers contributed 543 hours of service to forest-focused scientific studies and monitoring programs. They monitored beech trees for signs of beech leaf disease, an emerging threat likely to have significant impact on Virginia’s beech forests. Through the Nature’s Notebook project, volunteers documented seasonal changes in trees to better understand climate change impacts. Volunteers also supported American chestnut restoration research, including planting, measuring, maintaining, and inoculating trees in research plots. Additional volunteers contributed to a new study documenting Eastern Hemlock trees with potential genetic resistance to the invasive hemlock woolly adelgid. VMN volunteers also identified, measured, and mapped trees for a city-wide forest inventory in Newport News and measured trees for Virginia’s Big Tree registry. These contributions strengthen local, state, and national databases used by scientists and natural resource professionals to guide forest management decisions.
Nearly 700 VMN volunteers contributed 8,900 hours of on‑the‑ground stewardship for Virginia’s forests. Volunteers partnered with community groups to reduce the impacts of invasive vines, planted trees in urban neighborhoods, parks, and conservation areas, and collected hundreds of pounds of acorns and walnuts for the Virginia Department of Forestry nurseries to support future reforestation projects. In Fairfax, Albemarle, Charlottesville, and Blacksburg, volunteers participated in “tree rescue” programs to free trees from invasive vines. In Fairfax County alone, volunteers rescued more than 500 trees across 15 parks and trained dozens of residents to continue these efforts on their own properties.

Volunteers also shared their knowledge and enthusiasm for trees and forests with people of all ages. They led tree identification hikes, gave presentations, helped youth explore forests on school field trips, distributed trees to homeowners, and educated residents about protecting their trees from invasive vines.

Public Value Statement
Through education, citizen science, and stewardship, the Virginia Master Naturalist program strengthens forests across the Commonwealth. Volunteer‑generated data improves scientific understanding of emerging threats such as beech leaf disease and supports forest management decisions at local, state, and national scales. Tree plantings, invasive vine removal, and community education enhance the resilience of urban and rural forests, improving air and water quality, wildlife habitat, and climate resilience for all Virginians. By empowering residents to take part in forest conservation, the program builds long‑term community capacity to steward one of Virginia’s most valuable natural resources.
